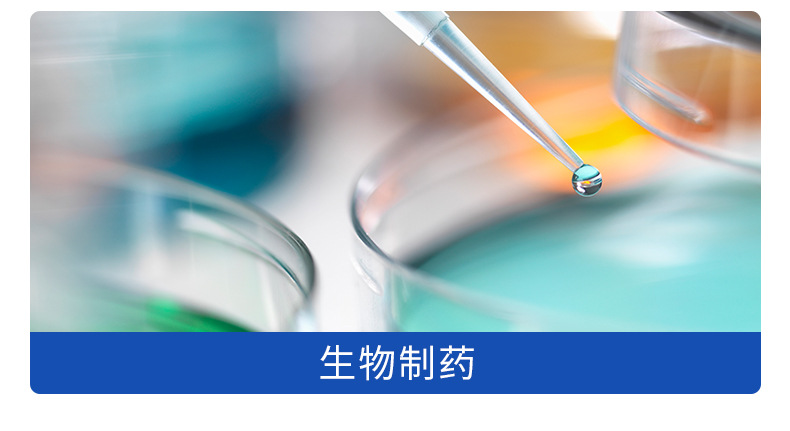

Четырехпроходные соединения Пластиковые пагоды крестовые четырехпроходные водопроводные водопроводные распределители для вентиляции воды Четырехпроходные соединения с высокой температурой
Вес:
0.09 кг
Продано за 30 дней:
2000 шт.
Всего продаж:
888555 шт.
Минимальное количество для заказа:
1 шт.
Четырехпроходные соединения Пластиковые пагоды крестовые четырехпроходные водопроводные водопроводные распределители для вентиляции воды Четырехпроходные соединения с высокой температурой
от 14.00 ₽ за 1 шт.
-21%
14.00 ₽
Доставка по Китаю включена в цену
Оптом
от 1 шт.
14.00 ₽
от 500 шт.
11.20 ₽
от 5000 шт.
9.80 ₽
Описание

Характеристики
Материал:
пластик
Номер товара:
10
Происхождение:
Цзянсу
Бренд:
должно быть надежным
Толщина трубки:
1
Толщина стенок:
1mm
Сорт:
1
Устойчивость к давлению:
7kg
Особые характеристики:
устойчив к коррозии
модель:
2.4-12.7mm
диаметр:
2.4-12.7
Технические характеристики продукта:
2.4mm; 3.2mm; 3.9mm; 4.8mm; 6.4mm; 7.9mm; 9.5mm; 11.1mm; 12.7mm; 5.6mm
Это специальный источник поставок для трансграничного экспорта?:
Нет
Четырехсторонний тип:
Обычный четырехсторонний
Категория:
Четырехсторонний
О продавце
Имя:
Оценка сервиса:
4.0
Оценка логистики:
4.1
Оценка споров и жалоб:
5.0
Оценка предложения:
5.0
Оценка консультации:
5.0
repeatPurchasePercent:
0.4986877389474844
afterSalesExperienceScore:
5.0
collect30DayWithin48HPercent:
1.0

Четырехпроходные соединения Пластиковые пагоды крестовые четырехпроходные водопроводные водопроводные распределители для вентиляции воды Четырехпроходные соединения с высокой температурой
14.00 ₽
14.00 ₽






